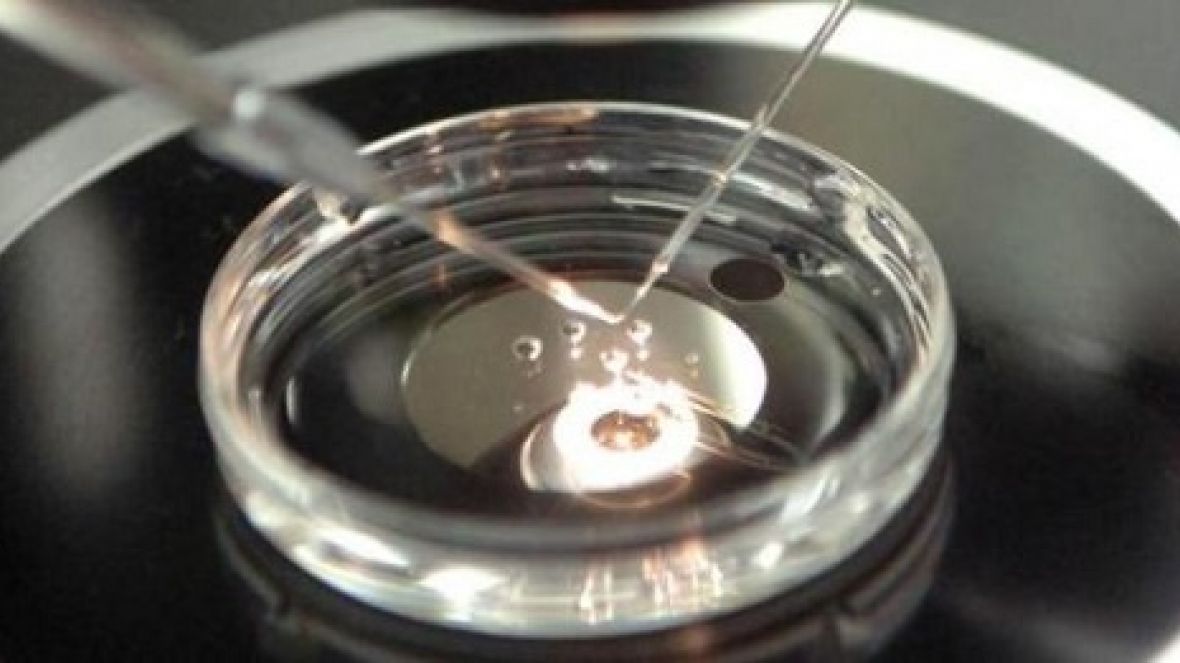
ABCZ comemora a firma do novo protocolo para a exportação de sêmen para a Índia

A ABCZ acredita que a confiança e a transparência são elementos essenciais no relacionamento com os seus usuários. Por isso, este aviso objetiva esclarecer sobre o uso de cookies no sítio eletrônico da Associação (https://www.abcz.org.br/) e páginas relacionadas, a fim de que o usuário possa compreender como ocorre o tratamento de seus dados de navegação.
O QUE SÃO COOKIES?
Cookies são pequenos arquivos de textos que são armazenados no seu computador ou dispositivo móvel – como tablet ou smartphone – quando você visita sites e outras páginas da web e que servem para atender diversas finalidades, dentre as quais distinguir o comportamento do usuário e melhorar a sua experiência de navegabilidade e uso do site.
PARA QUAIS FINALIDADES OS COOKIES SÃO UTILIZADOS PELA ABCZ?
A ABCZ coleta os chamados cookies necessários, utilizados com o objetivo de fornecer o funcionamento e a navegabilidade básica do site da ABCZ. Todos os sites precisam dessa categoria de cookies para funcionar corretamente, abrangendo atividades específicas de funcionamento do site e de seus serviços online, como, por exemplo, o acesso a áreas privadas por meio de login e senha.
QUAIS AS CATEGORIAS DE COOKIES UTILIZADOS PELA ABCZ?
A ABCZ poderá fazer uso das seguintes categorias de cookies:
|
Categoria
|
Descrição
|
|
Cookies necessários
|
São aqueles cookies utilizados para assegurar que o site, suas aplicações e serviços funcionem corretamente enquanto você navega. Sem eles, o site pode apresentar erros de funcionalidade e navegação. Essa categoria se restringe ao essencial para o funcionamento do site e de seus serviços, não contemplando finalidades que atendam a outros interesses da Associação.
|
É PRECISO AUTORIZAR O USO DE COOKIES?
Conforme observado no tópico anterior, a ABCZ utiliza somente cookies considerados estritamente necessários para garantir que o site realize funções básicas e opere corretamente. Em razão disso, a coleta desses cookies, considerados necessários, é essencial para assegurar o funcionamento do sítio eletrônico e para garantir a adequada navegação do usuário, não sendo exigível o aceite do usuário.
A ABCZ valoriza a privacidade e a proteção de dados dos seus clientes e usuários e reafirma o seu compromisso com a transparência e a boa-fé. Assim, quaisquer alterações nas finalidades ou nas categorias de cookies utilizadas pela Associação serão expressas ao usuário por meio do banner de Cookies e da atualização do presente Aviso.
Caso opte pela eliminação dos cookies necessários coletados, o usuário poderá buscar pela opção de gerenciamento e remoção de dados de navegação nas configurações de seu navegador de preferência. O usuário deve estar ciente que a remoção dos cookies poderá impossibilitar o funcionamento do site da ABCZ, bem como de serviços, aplicações e preferências personalizáveis de acesso, impossibilitando uma experiência de navegabilidade adequada.
Para mais informações quanto à privacidade do usuário, a ABCZ disponibiliza uma Política de Privacidade contendo todas as informações sobre a coleta e o armazenamento de dados pessoais, com base na Lei Geral de Proteção de Dados Pessoais – LGPD.
POR QUANTO TEMPO OS COOKIES SÃO ARMAZENADOS?
A ABCZ utiliza cookies que possuem diferentes períodos de armazenamento:
-
Cookies de sessão: são cookies temporários, isto é, que permanecem armazenados no seu computador ou dispositivo móvel por um período determinado de tempo;
-
Cookies persistentes: são cookies que continuam armazenados no seu computador ou dispositivo móvel até que sejam excluídos pelo usuário.
COMPARTILHAMENTO COM TERCEIROS
A ABCZ poderá compartilhar informações com parceiros para as finalidades informadas no item 6 do presente Aviso, respeitados os dispositivos previstos na Lei Geral de Proteção de Dados – LGPD.
ATUALIZAÇÃO
A ABCZ poderá atualizar o presente Aviso de Cookies a qualquer tempo, sem aviso prévio. As mudanças serão válidas assim que a versão atualizada for publicada no site da Associação. Por isso, é aconselhável que o usuário revisite o Aviso em intervalos periódicos.
CONTATOS
Em caso de dúvidas ou questionamentos sobre o presente Aviso de Cookies ou a nossa Política de Privacidade, bem como operações de tratamento que envolvem os seus dados de navegação, você poderá contatar a ABCZ por meio dos seguintes endereços eletrônicos:
comitelgpd@abcz.org.br
dpo@abcz.org.br